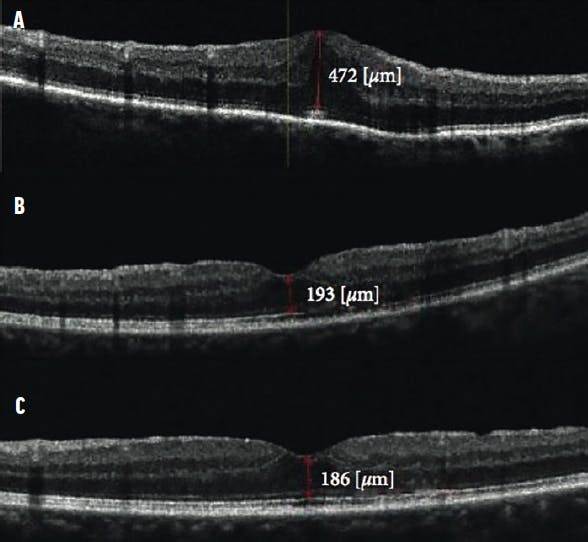
<p>Figure 1. These OCT scans show a patient who underwent limited vitrectomy with ERM removal. The preoperative scan (A) shows the ERM with CMT of 472 µm with BCVA measuring 0.5 logMAR. The 1-month postoperative scan (B) shows CMT reduced to 193 µm with BCVA improvement to 0.8. The 1-year follow-up scan (C) shows CMT of 186 µm with normal foveal contour and vision improvement to 0.9 logMAR.</p>

AT A GLANCE
- It may be prudent to perform a limited vitrectomy alone when the peripheral vitreous cortex and vitreous base are challenging to excise and the case is not associated with most macular pathologies.
- The authors found no significant differences between eyes that underwent limited versus complete vitrectomy in terms of BCVA, macular thickness, or other postoperative complications such as cystoid macular edema.
- The surgical time was significantly reduced in the limited vitrectomy group with more than 90% of surgeries completed in less than 1 hour.
Traditional vitreoretinal surgical teaching emphasizes that the entire vitreous must be removed in any form of vitreoretinal surgery.1 Although this rule may hold in cases of rhegmatogenous retinal detachment (RRD) and other pathologies in which the peripheral vitreous cortex is causative, it may not be true for eyes with predominantly macular pathologies.
Performing a complete vitrectomy with base dissection is time-consuming and requires a panoramic wide-angle viewing system for proper visualization. The procedure is dependent on a skilled assistant’s ability to bring the extreme peripheral cortex and ora serrata into view, and it is associated with the risk of lens touch and subsequent cataract formation in phakic eyes.
Because it is challenging to excise the peripheral vitreous cortex and vitreous base and these structures are unlikely to be associated with most macular pathologies, it may be prudent to forgo base excision and perform limited vitrectomy alone in these cases.2
However, leaving the pre-equatorial residual vitreous skirt in place may increase the risk of retinal tears and predispose vitrectomized eyes to RRD. Bonfiglio et al reported the use of limited vitrectomy for phakic eyes with RRD but without macular pathology with excellent results.3 Although Boscia et al proposed the use of minimal vitrectomy up to the equator almost a decade ago,4 no follow-up studies have established the safety of this approach.
We performed a multicenter retrospective study to compare the efficacy of limited vitrectomy versus complete vitrectomy with base excision in eyes with epiretinal membranes (ERM). Surgical times and complication rates were secondary outcomes.
METHODS
We used electronic health records and OR registers to identify all patients with idiopathic ERMs who underwent standard three-port pars plana vitrectomy (PPV) with or without combined phacoemulsification and IOL implantation with a minimum of 6 months follow-up at four institutions. Eyes with other coexistent ocular pathologies such as corneal opacities, uveitis, and ERMs occurring secondary to other retinal pathologies such as trauma, previous RRD, or retinal vascular disorders were excluded. Patients with diabetes with any sign of retinopathy or maculopathy were also excluded.
Intraoperative complications, especially peripheral retinal tears and the need for laser photocoagulation, were noted. The duration of surgery was recorded in five categories: 30 to 45 minutes, 46 to 60 minutes, 61 to 90 minutes, 91 to 120 minutes, and more than 120 minutes. Data gathered during follow-up visits at 1 week, 6 months, and final follow-up included BCVA, central macular thickness (CMT), and complications (Figures 1 and 2).
Figure 1. These OCT scans show a patient who underwent limited vitrectomy with ERM removal. The preoperative scan (A) shows the ERM with CMT of 472 µm with BCVA measuring 0.5 logMAR. The 1-month postoperative scan (B) shows CMT reduced to 193 µm with BCVA improvement to 0.8. The 1-year follow-up scan (C) shows CMT of 186 µm with normal foveal contour and vision improvement to 0.9 logMAR.

Figure 2. These OCT scans show a patient who underwent complete vitrectomy with ERM removal. The preoperative scan (A) shows the ERM with loss of foveal contour, CMT measuring 563 µm, and BCVA of 0.5 logMAR. The 1-month postoperative scan (B) shows a reduction in CMT to 266 µm and BCVA of 0.8 logMAR. At 1 year (C), CMT was 258 µm and BCVA had improved to 0.9 logMAR.
SURGICAL PROCEDURE
Standard three-port PPV was carried out under local anesthesia. Eyes with coexistent cataract underwent phacoemulsification with IOL implantation. In eyes that underwent limited vitrectomy alone, after three standard ports were created at the pars plana a posterior vitreous detachment (PVD) was induced up to the equator, and limited vitrectomy was completed without disturbing the peripheral cortical vitreous and vitreous base (Figure 3, Video 1).
In complete vitrectomy, PVD was induced up to the vitreous base, and the entire vitreous body, including the peripheral cortex and base, were removed to the extent possible (Figure 4, Video 2). In phakic eyes, the entire peripheral vitreous was removed. After vitrectomy, the ERM was stained and peeled using microforceps. The internal limiting membrane (ILM) was then stained and peeled around the center of the fovea for approximately 2 disc diameters (Figure 5). Ports were removed after application of tamponade. Eyes were filled with either saline or another tamponade per the surgeon’s choice.

Figure 4. In complete vitrectomy, the peripheral vitreous was removed, with vitreous base shaving using dynamic pre-equatorial scleral indentation.
RESULTS
Our analysis included 139 eyes of 139 patients. Sixty-five eyes (47%) underwent limited vitrectomy prior to ERM removal, and 74 eyes (53%) underwent complete vitrectomy with peripheral base excision. Patients undergoing limited vitrectomy were marginally younger, although this difference was not statistically significant (P = .06). More eyes in the limited vitrectomy group than in the complete vitrectomy group were phakic (P = .01). All other preoperative parameters were comparable between groups.
Table 1 illustrates the intraoperative characteristics of each group. Iatrogenic peripheral retinal tears occurred in eight eyes overall (6%) with no intergroup differences, and all tears received prophylactic intraoperative barrage laser. Surgical time was significantly shorter in the limited vitrectomy group, with more than 90% of surgeries completed in less than 1 hour compared with 70% in the complete vitrectomy group (Table 2).
After adjusting for possible confounders influencing duration of surgery such as operating surgeon, gauge of PPV used, lens status, and PVD status, we found that performing phacoemulsification along with PPV required an extra 3.4 minutes compared with PPV alone (P = .04).
A comparison of outcomes and complications between the groups at 6 months is shown in Table 3. The mean follow-up was 14.3 ± 2.3 months. At 1-week follow-up, BCVA had improved to 0.5 ± 0.2 logMAR in the limited vitrectomy group and 0.43 ± 0.2 logMAR in the complete vitrectomy group (P = .21). BCVA improved in both groups compared with baseline, and there was no difference in BCVA between groups at 6 months.
RRD was seen in two eyes (3%) in the limited vitrectomy group and no eyes in the complete vitrectomy group. None of the RRDs occurred in eyes that had experienced iatrogenic retinal tears during surgery. One detachment occurred 2 months after surgery and another 10 months after surgery. Both underwent successful retinal reattachment surgery with silicone oil tamponade. Self-limiting cystoid macular edema was the most common complication, seen in fewer than 10% of patients in each group.
DISCUSSION
In this multicenter retrospective European study, we found that performing limited vitrectomy along with ERM peeling yielded results comparable with those achieved with complete vitrectomy with base excision. Both study groups experienced the same number of iatrogenic retinal tears during surgery, and the incidence was not statistically significant between groups. Limited vitrectomy was significantly faster, with most surgeries taking less than 1 hour.
Boscia et al, in a noncomparative study, performed limited vitrectomy in 176 eyes with ERM and vitreomacular traction syndrome with favorable results.4 At a mean follow-up of 15 months, they reported excellent visual and anatomic results with RRD in only two eyes (1%). Similarly, Ozkaya et al performed limited vitrectomy with membrane peeling for ERM and idiopathic macular hole in 52 eyes.2 They noted a transient rise of IOP in three (5.9%) patients, endophthalmitis in one (2.0%) patient, and RRD in one patient (2.0%) during follow-up. In our comparative study, we found similar results in the limited vitrectomy group, with RRD occurring in only two eyes.
The main concern with performing limited vitrectomy for macular pathologies is the possibility of condensation and contraction of the residual peripheral vitreous cortex. This may then lead to an increased risk of retinal tears with subsequent RRD. The incidence of retinal detachment has varied from 1% to 18% in previous studies.5-8 In a large multicenter study of 474 eyes with macular pathologies, Matonti et al reported that iatrogenic retinal breaks were seen in 1.7% of cases, and an additional 2.7% experienced RRD.5 In another large study of more than 1,600 eyes in which an ultrahigh-speed 25-gauge cutter was used, Mura et al reported that the risk of iatrogenic breaks (1.8%, n = 25) was higher when PVD was induced intraoperatively.6
Tarakcioglu et al postulated that induction and extension of PVD or performing peripheral vitreous shaving could be a cause of iatrogenic peripheral retinal tears.9 Rahman et al reported a much higher incidence of iatrogenic retinal breaks (18%) in eyes with macular pathologies and attributed this to a more adherent posterior hyaloid.8 Thus, it may be prudent not to induce a PVD beyond the equator when vitrectomy is performed for macular pathologies. Before concluding such surgeries, clinicians must perform a detailed examination of the periphery with indentation and prompt laser treatment when necessary.
Our study showed that performing limited vitrectomy along with ERM and ILM peeling was significantly faster than performing complete vitrectomy in most instances. Reduced surgical time may improve surgical performance, especially in a high-volume surgical setup. Additionally, a patient’s subjective experience may also be better with a shorter surgical time. We did not find any other significant differences between eyes that underwent limited versus complete vitrectomy in terms of BCVA, macular thickness, or other postoperative complications such as cystoid macular edema.
FINAL THOUGHTS
The merits of our study include its multicentric nature and the inclusion of a comparison group. The study was limited by its retrospective nature, relatively small sample size, and few cases of retinal tears and detachments, making safety assessment a challenge. The findings may have limited utility in eyes with complex ERMs, for which the surgical time may be prolonged.
In summary, we found that limited vitrectomy was at least as effective as complete vitrectomy in the management of macular pathologies. Limited vitrectomy also reduced operative time without increasing the rate of complications. Further prospective, randomized studies with larger sample sizes will be required to confirm these observations.
1. Sullivan P. Vitreoretinal Surgery. London: Eyelearning; 2014:306.
2. Ozkaya A, Erdogan G, Tulu B, Tarakcioglu HN. The outcomes of subtotal vitrectomy in macular surgeries: a single surgeon case series. Int Ophthalmol. 2019;39(3):589-595.
3. Bonfiglio V, Toro MD, Longo A, et al. Modified vitrectomy technique for phakic rhegmatogenous retinal detachment with intermediate break. J Ophthalmol. 2018;6127932.
4. Boscia F, Milano A, Sborgia G, et al. Minimal vitrectomy for epiretinal membranes and vitreomacular traction syndrome. Invest Ophthalmol Vis Sci. 2009;50(13):4208-4208.
5. Matonti F, Meyer F, Rouhette H, et al. Anatomical and functional prognosis of secondary retinal detachments after sutureless macular surgery. J Fr Ophtalmol. 2014;37(1):58-63.
6. Mura M, Barca F, Dell’Omo R, et al. Iatrogenic retinal breaks in ultrahigh-speed 25-gauge vitrectomy: a prospective study of elective cases. Br J Ophthalmol. 2016;100(10):1383-1387.
7. Rizzo S, Belting C, Genovesi-Ebert F, et al. Incidence of retinal detachment after small-incision, sutureless pars plana vitrectomy compared with conventional 20-gauge vitrectomy in macular hole and epiretinal membrane surgery. Retina. 2010;30(7):1065-1071.
8. Rahman R, Murray CD, Stephenson J. Risk factors for iatrogenic retinal breaks induced by separation of posterior hyaloid face during 23-gauge pars plana vitrectomy. Eye. 2013;27(5):652-656.
9. Tarakcioglu HN, Tulu B, Ozkaya A. Subtotal vitrectomy in idiopathic macular hole surgery. Saudi J Ophthalmol. 2019:33(4):369-373.


























